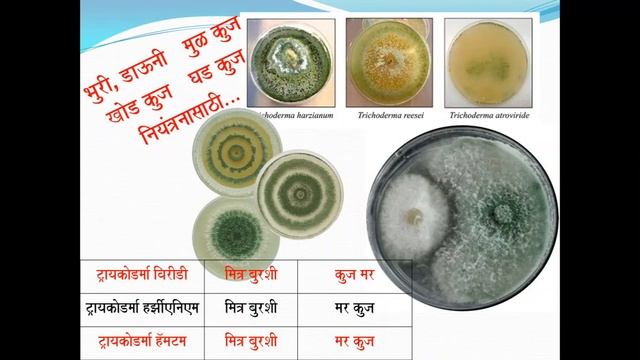
Beneficial microbs in agriculture शेतीतील उपयुक्त सूक्ष्मजीव смотреть онлайн

Автор: Грибные украшения для свадьбы Страница 3

Необычное платье для Нового Года

НА ОЗЕРЕ 🌅СУНГУЛЬ/СОБРАЛИ УРОЖАЙ🥒🍅🍓СОБИРАЕМ ГРИБЫ👍

MycoClinics 4: Mycetoma; and Candida and conduits

Köp Vaccumpump Hilti DD VP-U på Klaravik

Кто это сделал и зачем? #shorts #лес #грибы #находка

Пригоди мишенятка 1# симулятор маленької мишки ігра-мульт для діток
Beneficial microbs in agriculture शेतीतील उपयुक्त सूक्ष्मजीव

ОЭК vs Профсоюз скотозабойщиков

Асортимент крамниці Центру Здоров'я ВЕСЕЛКА станом на 01.07.2023р.

Лена Хеппи. Селим таки муж? Сентябрь- финансовый провал. Подозрительный Братец

Ядро Малкух // Lobotomy Corporation #15

Осенние Опята- - это Песня

Переслушал

Чара-хранители ( Тает лёд ) - заказ

Շոկոլադե երշիկ, 90-ականների ամենահամեղ բաղադրատոմսերից Chocolate Salami Recipe Шоколадная Салями

Полную версию ищи по названию "Доклад о будущем Человечества"#глобальныйкризис #катаклизмы

Печать

РомГермТВ. Серебряные строки: Екатерина Ищенко

Клип Сати Казанова Чувство лёгкости есть

Тром 8-17

Лес и птички в начале мая ! Удмуртская республика

NHÂN SINH KHỐI VI SINH MỸ, XEM THẾ NÀO

Cápsula 09 - Botrytis cinerea

Памятник павшим солдатам
За каждым успешным каналом стоит личность, идея и сотни часов кропотливого труда. Если вы здесь, значит, автор «Грибные украшения для свадьбы» уже сумел зацепить ваше внимание своим уникальным стилем или подачей. А мы на RUVIDEO позаботились о том, чтобы вы могли изучить весь архив его работ в максимально комфортных условиях — без лишней суеты и преград.
Почему за работами канала «Грибные украшения для свадьбы» так интересно наблюдать? Всё просто: это честный контент, который находит отклик в сердцах зрителей. На нашем ресурсе вы можете смотреть онлайн все видео любимого автора бесплатно и в хорошем качестве. Нам важно, чтобы вы видели каждую деталь и слышали каждый нюанс, поэтому мы используем только стабильные плееры из открытых источников Rutube.
Следите за новинками канала, пересматривайте старые шедевры и открывайте для себя новые грани творчества «Грибные украшения для свадьбы». Мы постоянно обновляем ленту, чтобы у вас под рукой всегда были самые свежие выпуски. Никаких сложных регистраций — только вы и творчество, которое вдохновляет. Приятного вам путешествия по миру авторского контента на RUVIDEO!
Видео взято из открытых источников Rutube. Если вы правообладатель, обратитесь к первоисточнику.